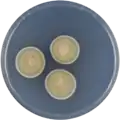
Aspergillus microcysticus growing on CYA plate

| Aspergillus microcysticus | |
|---|---|
| Scientific classification | |
| Domain: | Eukaryota |
| Kingdom: | Fungi |
| Division: | Ascomycota |
| Class: | Eurotiomycetes |
| Order: | Eurotiales |
| Family: | Aspergillaceae |
| Genus: | Aspergillus |
| Species: | A. microcysticus |
| Binomial name | |
| Aspergillus microcysticus | |
| Type strain | |
| ATCC 16826, BCRC 33360, CBS 120.58, CCRC 33360, IMI 139275, NRRL 4749, QM 8158, WB 4749[3] | |
Aspergillus microcysticus is a species of fungus in the genus Aspergillus.[1][4] Aspergillus microcysticus produces aspochalasin A, aspochalasin C, aspochalasin D, and the antibiotic asposterol.[5][6][7][8][9]
Growth and morphology
A. microcysticus has been cultivated on both Czapek yeast extract agar (CYA) plates and Malt Extract Agar Oxoid® (MEAOX) plates. The growth morphology of the colonies can be seen in the pictures below.
Aspergillus microcysticus growing on CYA plate
Aspergillus microcysticus growing on CYA plate Aspergillus microcysticus growing on MEAOX plate
Aspergillus microcysticus growing on MEAOX plate
References
- 1 2 "Aspergillus microcysticus". www.mycobank.org.
- ↑ Samson, ed. by Robert A.; Pitt, John I. (2000). Integration of modern taxonomic methods for penicillium and aspergillus classification. Amsterdam: Harwood Acad. Publ. ISBN 978-9-058-23159-8.
{{cite book}}:|first1=has generic name (help) - ↑ "Aspergillus microcysticus Taxon Passport - StrainInfo". www.straininfo.net.
- ↑ "Aspergillus". www.uniprot.org.
- ↑ Heberle, Wolfgang (1 January 1974). "Asposterol, ein antibiotikum aus aspergillus microcysticus; unt…" (in German).
{{cite journal}}: Cite journal requires|journal=(help) - ↑ Brossi, Arnold, ed. (1991). The Alkaloids, 40. Burlington: Elsevier. ISBN 978-0-080-86564-5.
- ↑ Dictionary of natural products (1. ed.). London [u.a.]: Chapman & Hall. 1994. ISBN 978-0-412-46620-5.
- ↑ Betina, Vladimír, ed. (1993). Chromatography of mycotoxins techniques and applications. Amsterdam: Elsevier. ISBN 978-0-080-85862-3.
- ↑ Keller-Schierlein, Walter; Kupfer, Ernst (17 July 1979). "Stoffwechselprodukte von Mikroorganismen. 186. Mitteilung. Über die Aspochalasine A, B, C und D". Helvetica Chimica Acta. 62 (5): 1501–1524. doi:10.1002/hlca.19790620516.
Further reading
- Machida, edited by Masayuki; Gomi, Katsuya (2010). Aspergillus : molecular biology and genomics. Wymondham, Norfolk, UK: Caister Academic. ISBN 978-1-904-45553-0.
{{cite book}}:|first1=has generic name (help) - Gunstone, senior reporter F.D. (1981). Aliphatic and related natural product chemistry. London: Royal Society of Chemistry. ISBN 978-0-851-86652-9.
- Samson, R.A.; Peterson, S.W.; Frisvad, J.C.; Varga, J. (June 2011). "New species in Aspergillus section Terrei". Studies in Mycology. 69 (1): 39–55. doi:10.3114/sim.2011.69.04. PMC 3161753. PMID 21892242.
This article is issued from Wikipedia. The text is licensed under Creative Commons - Attribution - Sharealike. Additional terms may apply for the media files.